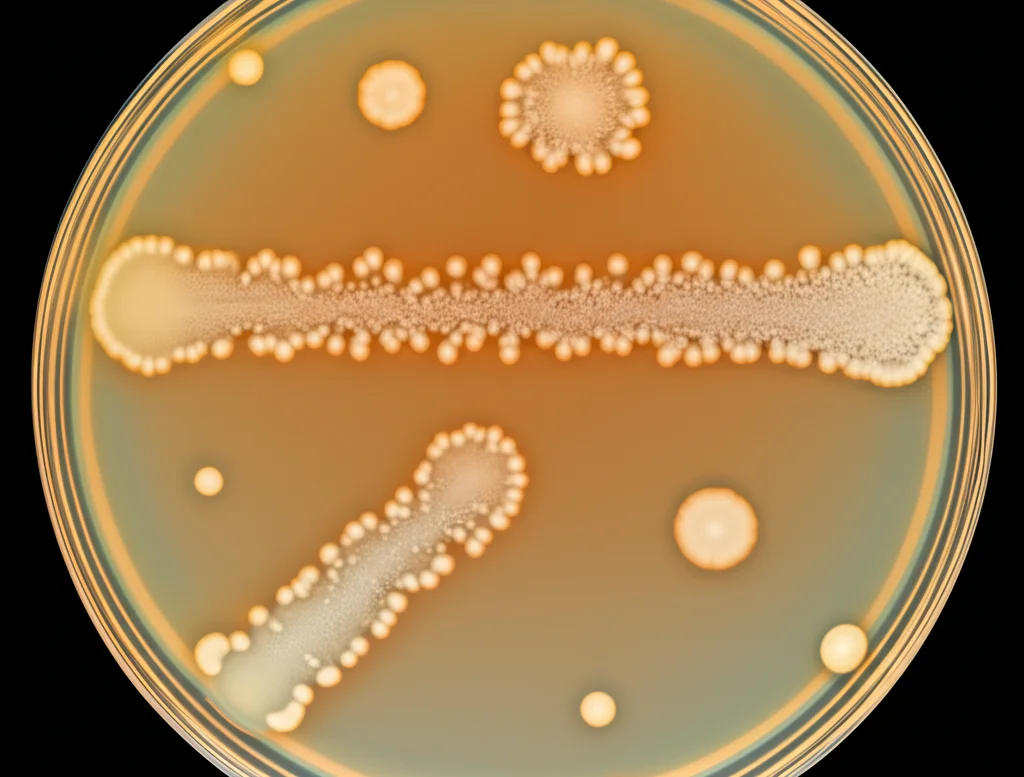
Microbiologia: Piastra di Petri con colonie batteriche isolate da un campione fecale umano, vista macro con lente da 90mm, illuminazione controllata da laboratorio, alta definizione dei dettagli delle colonie biancastre su terreno di coltura scuro.

Vi presento Bacteroides maternus: Un Nuovo Abitante del Nostro Intestino!
Ciao a tutti, appassionati di scienza e curiosi del mondo invisibile che ci abita! Oggi voglio portarvi con me in un viaggio affascinante all’interno del nostro corpo, più precisamente nel nostro intestino, un ecosistema brulicante di vita che chiamiamo microbioma. Pensate, ospitiamo trilioni di microrganismi, soprattutto batteri, che lavorano incessantemente per noi, influenzando la nostra digestione, il nostro sistema immunitario e persino il nostro umore!
Un universo dentro di noi: il Microbioma Intestinale
Il tratto gastrointestinale umano è una vera metropoli microbica. Qui, batteri di diversi phyla, come i Bacteroidota e i Bacillota, convivono e interagiscono. Tra i protagonisti indiscussi di questo ambiente c’è il genere Bacteroides. Questi batteri sono dei veri campioni: sono anaerobi (vivono senza ossigeno), Gram-negativi, a forma di bastoncello e, soprattutto, sono dei maestri nel digerire polisaccaridi complessi, quelle fibre che noi non riusciamo a scomporre, grazie a speciali “cassette degli attrezzi” genetiche chiamate PULs (Polysaccharide Utilisation Loci).
I Bacteroides sono fondamentali per la nostra salute. Bassi livelli di questi batteri sono stati collegati a problemi come l’obesità e il diabete. Attenzione però, come in ogni ecosistema complesso, c’è anche un lato oscuro: alcune specie di Bacteroides possono diventare patogeni opportunisti, causando infezioni se le condizioni lo permettono.
La scoperta: un nuovo batterio dalla mamma!
Ed è proprio studiando questo affascinante mondo, in particolare durante ricerche sul microbioma nelle prime fasi della vita, gravidanza e puerperio, che ci siamo imbattuti in qualcosa di… nuovo! Da un campione di feci di una mamma irlandese/caucasica in perfetta salute, quattro settimane dopo un parto vaginale, abbiamo isolato un ceppo batterico che sembrava diverso da tutti gli altri. Lo abbiamo chiamato, per ora, MSB163. È importante sottolineare che la donatrice non aveva assunto antibiotici né probiotici nel periodo precedente il prelievo.
Abbiamo subito iniziato le indagini, un po’ come dei detective del microcosmo. Prima abbiamo usato tecniche di biologia molecolare (PCR e sequenziamento del gene 16S rRNA) per capire a quale “famiglia” appartenesse. Risultato: genere Bacteroides. Ma c’era qualcosa che non tornava, non corrispondeva a nessuna specie già nota. Era il momento di andare più a fondo!
L’identikit genetico e biochimico di MSB163
Per svelare l’identità di MSB163, abbiamo sequenziato il suo intero genoma. Immaginate di leggere l’intero libretto di istruzioni di questo batterio! Abbiamo scoperto che ha un genoma di circa 6,4 milioni di paia di basi (un bel po’!) con un contenuto di GC (Guanina-Citosina, due mattoncini del DNA) del 42,95%. Curiosamente, abbiamo trovato anche due piccoli genomi circolari extra, chiamati plasmidi. Uno di questi conteneva persino geni legati alla resistenza a un antibiotico (la clindamicina) e al metabolismo degli zuccheri, anche se poi, nei test, il batterio si è rivelato sensibile a quell’antibiotico. Misteri della biologia!
Con il genoma completo in mano, abbiamo potuto confrontarlo con tutte le specie di Bacteroides conosciute. Il parente più stretto è risultato essere Bacteroides cellulosilyticus. Ma quanto stretto? Abbiamo usato due metriche potentissime: l’Average Nucleotide Identity (ANI) e la digital DNA:DNA hybridization (dDDH). Pensatele come un test di somiglianza genetica super avanzato. Per essere considerati della stessa specie, i batteri devono avere un ANI superiore al 95% e un dDDH superiore al 70%. Bene, il nostro MSB163 ha mostrato un ANI del 94,51% e un dDDH del 53,80% rispetto a B. cellulosilyticus. Bingo! Questi valori sono sotto le soglie convenzionali, confermando che avevamo tra le mani una nuova specie!
Caratteristiche uniche del nuovo arrivato
Ma non ci siamo fermati alla genetica. Abbiamo studiato MSB163 da vicino:
- Aspetto: È un batterio Gram-negativo, a forma di bastoncello (lungo da 1,6 a 2,4 micrometri), non si muove e forma colonie biancastre, circolari e leggermente rialzate su terreno di coltura.
- Condizioni ideali: Ama stare al calduccio a 37°C (la nostra temperatura corporea!), preferisce un pH neutro (intorno a 7) e non gradisce il sale (cresce meglio senza NaCl).
- Biochimica: Produce specifici chinoni respiratori (MK-10 e MK-11) e ha un profilo di acidi grassi cellulari particolare, con l’acido C15:0 ANTEISO come componente principale. Ma la vera sorpresa è arrivata dall’analisi dei lipidi polari della sua membrana: manca il fosfatidilglicerolo, un componente solitamente presente nei suoi parenti più stretti come B. cellulosilyticus e B. intestinalis. Una differenza chiave!
- Metabolismo: È risultato positivo al test della catalasi (un enzima che neutralizza il perossido di idrogeno), cosa inaspettata perché la descrizione originale di B. cellulosilyticus lo dava come negativo (anche se poi abbiamo verificato che anche lui ha il gene per la catalasi!). È anche capace di convertire il glutammato in GABA (acido gamma-amminobutirrico), un importante neurotrasmettitore, grazie all’attività dell’enzima GAD. Sa fermentare un sacco di zuccheri (glucosio, lattosio, xilosio, ecc.), ma la cosa interessante è che, con un po’ più di tempo (48 ore), riesce a fermentare anche melezitosio e sorbitolo, a differenza dei suoi parenti stretti. Non sembra invece capace di utilizzare il 2′-Fucosillattosio (2′-FL), uno zucchero importante presente nel latte materno.

Benvenuto, Bacteroides maternus!
Tutte queste prove – genetiche, morfologiche, fisiologiche e biochimiche – ci hanno permesso di affermare con certezza che MSB163 rappresenta una specie batterica mai descritta prima. Abbiamo quindi proposto un nome che onorasse la sua origine: Bacteroides maternus (dal latino “maternus”, che significa materno, relativo alla madre).
Questa scoperta è entusiasmante! Non solo aggiunge un nuovo membro alla già vasta e importante famiglia dei Bacteroides, ma ci ricorda quanta biodiversità microbica ancora si nasconda nel nostro intestino e quanto sia cruciale continuare ad esplorare questo ecosistema, specialmente in momenti delicati e importanti come il periodo post-partum per la mamma. Capire chi sono questi microrganismi e cosa fanno è fondamentale per comprendere meglio la salute umana e sviluppare future strategie per mantenerla o migliorarla.
Il ceppo tipo, MSB163, è stato depositato in collezioni internazionali di colture microbiche (BCCM/LMG e DSMZ) ed i suoi dati genomici sono accessibili pubblicamente (NCBI BioSample SAMN39531295), a disposizione della comunità scientifica per ulteriori studi.
Il viaggio alla scoperta del microbioma è appena iniziato, e ogni nuova specie come Bacteroides maternus è un tassello in più in questo incredibile puzzle della vita dentro di noi!
Fonte: Springer
